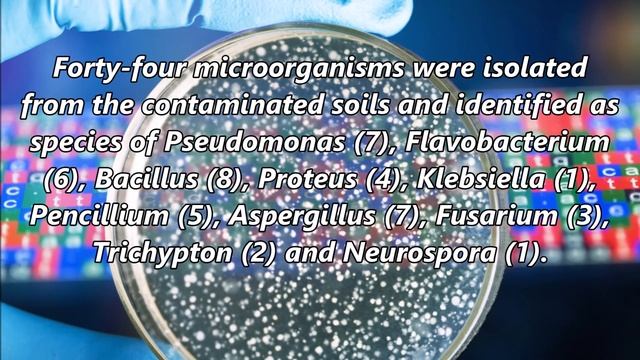
Biotreatment of Crude Oil Contaminated Soil смотреть онлайн

Автор / Канал: Первые шаги в программировании Страница 4

Need for Speed Workshop Bentley Continental (Джаггернаут)

Товары или Аксессуары для Рено Дастер ,Ниссан Террано. (Часть 1)

WOT: Руинберг - E-100 - 6 фрагов -

Flooder VKontakte

Milotic is a Marvel! Pokémon Sword and Shield Wi-Fi Battle

Jarvis tutorial 11?? | Make your own voice assistant | Python programming #jarvis #voiceassistant

Tryhackme | THM Startup CTF

Матвеева Софья. Диплом.
![[HOT NEWS] 2018 Mazda 6 Gets 250 HP Turbo Treatment - New Interior For Debut смотреть онлайн [HOT NEWS] 2018 Mazda 6 Gets 250 HP Turbo Treatment - New Interior For Debut смотреть онлайн](https://pic.rtbcdn.ru/video/d9/27/d927c991dc160a565bd4b565b06ec78c.jpg)
[HOT NEWS] 2018 Mazda 6 Gets 250 HP Turbo Treatment - New Interior For Debut

HTML : insert ads on HTML5 video

География - это...

Битрикс24 и 1C:ERP: согласование заявки на расход денежных средств (интеграция)

2. Dev muhitni yaratish, kerakli dasturlarni o'rnatish. | PHP dasturlash tili o'rganish

DROD: Entropy - E10: Order
Biotreatment of Crude Oil Contaminated Soil

047 Troubleshooting Entity Validation Errors MVC C# Asp.NET

Exiled Kingdoms Quest Walkthrough - Fort Assault

Samsung Galaxy Z Flip 4: BIGGEST LEAK Yet?! (Specs, Design) & more!

Компас в iPhone 4 (25/30)

Subaru Tribeca B9 снег offroad 4x4

Let's Play Witcher 2 Episode 66
![X3 Terran Conflict - Fight Trailer [HQ] смотреть онлайн X3 Terran Conflict - Fight Trailer [HQ] смотреть онлайн](https://pic.rtbcdn.ru/video/f1/3d/f13dbbe109075ca0a2f54c2b30c43086.jpg)
X3 Terran Conflict - Fight Trailer [HQ]

Photo ID animation meme! ib: @Honeykitty

Taxback Group Career Start
За каждым успешным каналом стоит личность, идея и сотни часов кропотливого труда. Если вы здесь, значит, автор «Первые шаги в программировании» уже сумел зацепить ваше внимание своим уникальным стилем или подачей. А мы на RUVIDEO позаботились о том, чтобы вы могли изучить весь архив его работ в максимально комфортных условиях — без лишней суеты и преград.
Почему за работами канала «Первые шаги в программировании» так интересно наблюдать? Всё просто: это честный контент, который находит отклик в сердцах зрителей. На нашем ресурсе вы можете смотреть онлайн все видео любимого автора бесплатно и в хорошем качестве. Нам важно, чтобы вы видели каждую деталь и слышали каждый нюанс, поэтому мы используем только стабильные плееры из открытых источников Rutube.
Следите за новинками канала, пересматривайте старые шедевры и открывайте для себя новые грани творчества «Первые шаги в программировании». Мы постоянно обновляем ленту, чтобы у вас под рукой всегда были самые свежие выпуски. Никаких сложных регистраций — только вы и творчество, которое вдохновляет. Приятного вам путешествия по миру авторского контента на RUVIDEO!
Видео взято из открытых источников Rutube. Если вы правообладатель, обратитесь к первоисточнику.